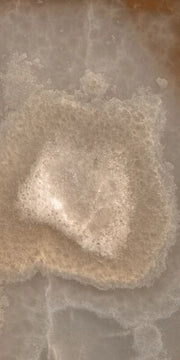
Reves Choco 12x24 Matte Porcelain Tile

Reves Choco 12x24 Matte Porcelain Tile
by Nirvala Tile
Original price
$8.70
-
Original price
$8.70
Original price
$8.70
-
$8.70
Current price
$8.70
per sq. ft.
$101.18
per box (11.63 sq. ft.)
Color:
Choco
Finish:
Size and shape:
12x24
Order sample
Samples ship in 4x4 or 6x6 swatches.